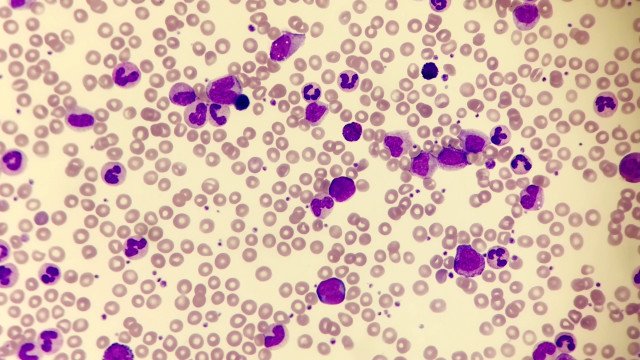

A Leucemia Mieloide Crônica é um tipo de câncer de origem desconhecida e considerado pelo Ministério da Saúde como uma doença rara. Considera-se doença rara aquela que afeta até 65 pessoas em cada grupo de 100 mil indivíduos. Assim como os demais tipos de leucemia, ataca os glóbulos brancos, afetando os leucócitos e tem como principal característica o acúmulo de células doentes na medula óssea, impedindo a produção de células saudáveis do sangue.
É uma doença de evolução lenta e progressiva. Uma característica bastante singular é a presença de anormalidade genética chamada de “cromossomo Philadelphia” em amostra da medula óssea ou sangue periférico, detectada em exame de biologia molecular. Esse cromossomo é formado pela troca de material genético, que resulta no cromossomo causador deste câncer. A mutação leva a uma produção anormal de glóbulos brancos, caracterizando a leucemia.
De acordo com Mayo Clinic, uma organização sem fins lucrativos focada na prática clínica, na educação e na investigação, este tipo de leucemia, na maioria dos casos não causa sintomas, mas quando ocorrem, a lista inclui:
Dores nos ossos;
Sangramento fácil;
Sentir-se cheio depois de comer uma pequena quantidade de comida;
Fadiga.
Febre;
Emagrecer sem esforço;
Perda de apetite.
Dores em baixo das costelas no lado esquerdo;.
Suor excessivo durante o sono;
Visão turva causada por hemorragia na parte de trás do olho.
Leia Também: Influencer morre de câncer aos 35 e posta despedida aos seguidores